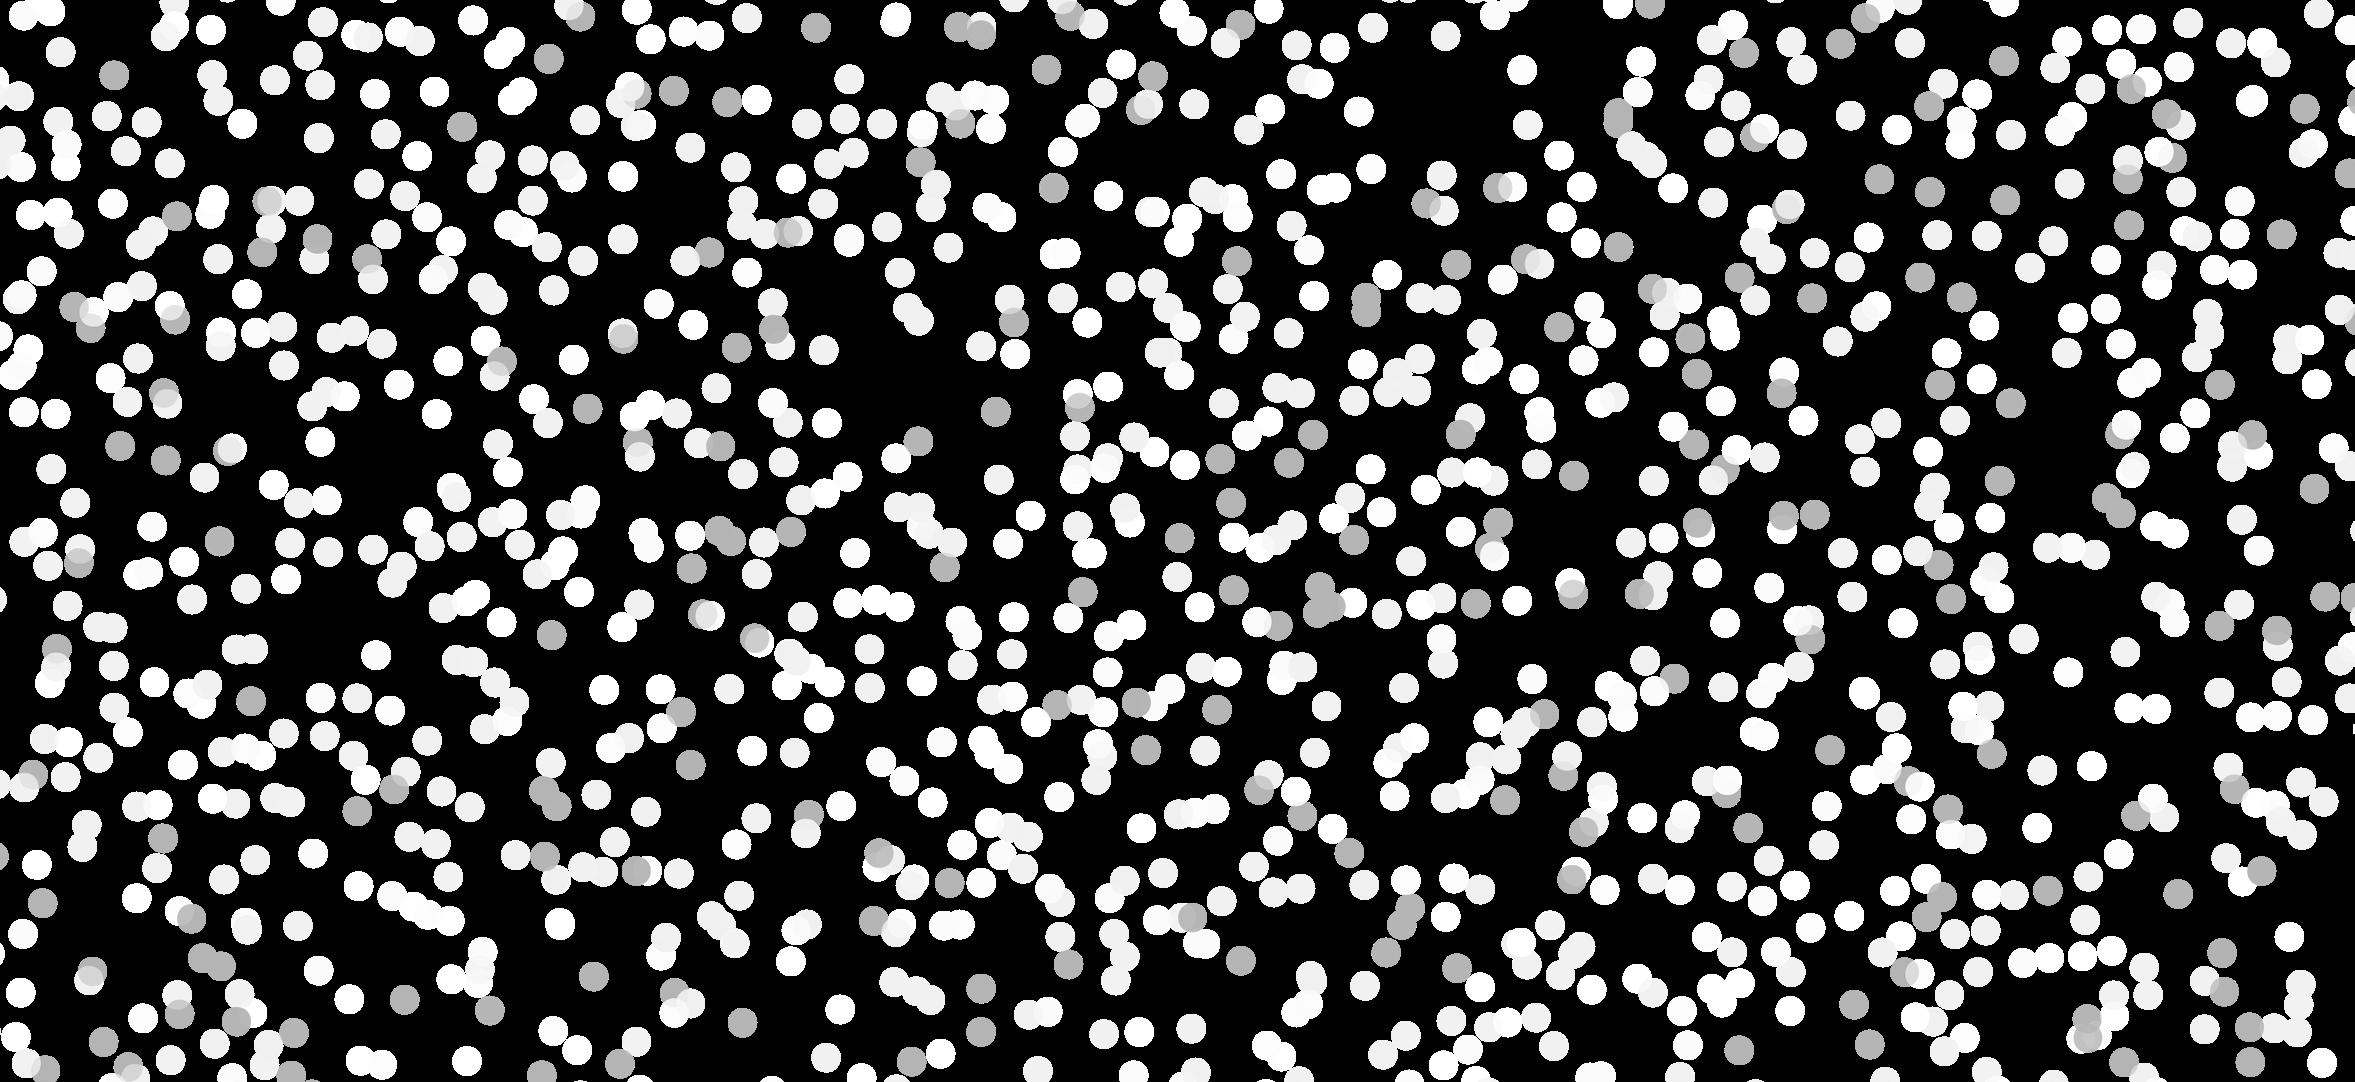

Materials
From the department head


Dear alumni, students, parents, and friends,
I’m delighted to share this edition of the MSE magazine and highlight the many exciting developments and accomplishments within our department over the past year.
In May, we had a joyous celebration of our 2025 graduates along with their families and loved ones at the MSE diploma ceremony. Fifty-six undergraduates received their degrees this spring, which was our largest undergraduate class in the department’s history! Celebrating our students and their accomplishments as they advance to the next chapter of their professional or academic paths is a joyful and meaningful occasion. We hope that you enjoy seeing images from the celebration.
Our research efforts continue to position Carnegie Mellon University at the forefront of growth and innovation in a wide range of materials applications, from advanced manufacturing techniques that could improve sustainability efforts, to life-changing biomedical interventions, to solutions for energy efficiency. Our faculty and students tackle pressing challenges that impact our society and fuel progress toward positive change.
We are proud to share the many honors and awards that our students, faculty and alumni have received over the past year. These recognitions from esteemed organizations such as ASM, TMS, AIME, MRS, and many more reflect the stature of our department. One of our newest faculty members, Ismaila Dabo, was named as a recipient of the Presidential Early Career Award for Scientists and Engineers. We are also pleased to share that Greg Rohrer was named a University Professor, joining Anthony Rollett in this highest university honor.
We love learning how our graduates make an impact in the world and encourage all of our alumni to keep in touch. Your connections with our students are invaluable - sharing your expertise in the classroom, recruiting on behalf of your companies, or supporting the MSE Student Impact Fund. You are all key partners in promoting the value and versatility of a CMU MSE degree.
If you plan to visit campus this year, I invite you to connect with me so that I can share other exciting departmental accomplishments and initiatives.

Beth Dickey
Teddy & Wilton Hawkins Distinguished Professor and Department Head of Materials Science & Engineering


PUBLISHER
EDITOR
Monica Cooney, Communications Manager
WRITERS
Monica Cooney, Stacey Federoff, Giordana
Verrengia, Sara Pecchia, Lynn Shea
DESIGN
Debra Vieira, Senior
Multimedia Designer, College of Engineering
Printed materials inspired by nature
Superhydrophobic materials are found in many forms in nature, from scales on shark skin that reduce drag to lotus leaves whose surface enables water to roll off and remove dirt particles in the process. The way in which water interacts with these surfaces in nature is inspiring the work of a team of researchers from Carnegie Mellon University.
A study published in Advanced Materials Technologies illustrates a new method for creating superhydrophobic surfaces using an aerosol jet printer and polymer solutions. The findings illustrate a technique through which polymer microgel particles are deposited onto a substrate in a specific pattern. This new method is unique in that it offers precise control over the shape and location of the structures, while requiring no post processing.
“The polymer we used is slightly hydrophobic and is widely utilized in wearables due to its durability and flexibility,” said professor of materials science and engineering Mohammad Islam, who contributed to the research.
“The superhydrophobicity of the surface can be attributed to its unique surface characteristics.”
Aerosol jet printing is an advanced additive manufacturing technique used to create precise components and structures by converting a liquid ink containing functional materials (i.e. metals, polymers, or ceramics) into a

“We found that jetting with a solvent having a high vapor pressure resulted in deposition of gelled spheres when they hit the surface, like micro-sized hail.”
- Gary Fedder, Faculty Director, Manufacturing Futures Institute
fine mist of tiny droplets that are carried by a gas to form an aerosol. A focused stream of aerosol is then deposited onto a substrate through a nozzle where the ink droplets exit and adhere to the substrate.
This process allows for high precision and versatility while using a variety of material types. In this study, three different solvents with varying vapor pressures were used. During the droplets’ transition from the printer nozzle to the substrate, the droplets transformed into microgel particles that created a rough, superhydrophobic surface.
“Usually aerosol jet printing results in droplets coalescing on the surface and then drying to form a thin film,” said co-author Gary Fedder. “However, we found that jetting with a solvent having a high vapor pressure resulted in deposition of gelled spheres when they hit the surface, sort of like microsized hail. The gelated spheres form the micron-sized surface texture while the printing enables fine patterning.”
Existing methods of achieving superhydrophobicity face challenges in regards to manipulating materials properties, as well as complexity and time investment. This method provides a less time-consuming, more controllable way to create superhydrophobic surfaces by manipulating the solvent evaporation rate and polymer gelation process during deposition.
As superhydrophobic materials offer numerous benefits across various industries, this discovery has potential for a wide range of applications. The materials could be effective in separating oil from water, which is useful in environmental cleanup and industrial processes. Retardation of droplet evaporation could result in improved efficiency in cooling systems and improvements in water conservation. Droplet manipulation could also improve energy efficiency by enhancing heat transfer in cooling systems.


Real-time sensors to inform better wound care
Wound assessment by medical professionals relies largely on visual inspection, which can be challenging due to its subjective nature. Nitric oxide (NO) plays an important role in healing, as it is produced by immune cells during inflammation and acts as a key signal to coordinate recovery. However, measuring NO in wounds is difficult for several reasons. It has a short lifespan, breaking down in a matter of seconds, so detection tools must work almost instantly to discover NO before it disappears. Additionally, NO exists in wounds at extremely low concentrations and most sensors aren’t sensitive enough to detect these trace levels. Fluid found in wounds can also contain bacteria and other substances that can skew measurements.
A new technology, the multiplexed, electrochemical, real-time, localized, inflammation-tracking nitric oxide (MERLIN) sensor array, has been developed by the Cohen-Karni research group to overcome these challenges. The chemical-electrical sensor, similar to a glucose monitor, quantifies biomarkers related to wound healing. Using flexible materials and multiple detection points to map NO levels across wounds, the technology will offer real time measurements that could improve the healing process.
Recent work published in Science Advances indicates promising results from in vivo testing on rat skin wounds. Over the course of seven days of testing, NO levels peaked on day three, reflecting the inflammation phase of wound healing, and falling in line with activity reported in previous studies. Following the promising outcomes from
these tests, the sensor is set to enter human trials at University of Pittsburgh Medical Center (UPMC).
“The sensors will help clinicians assess the state of a wound by directly measuring the levels of nitric oxide, a biomarker for the immune system response to the wound,” said Tzahi Cohen-Karni, professor of biomedical engineering and materials science and engineering.
The sensors were developed as a result of breakthroughs in wound care under a DARPA funded project in the Bioelectronics for Tissue Regeneration program. The latest work will provide support for diagnostic tools in addition to therapeutic interventions.
In testing these sensors, the research group, which included collaborators from Carnegie Mellon University, University of Pittsburgh, and Lake Erie College of Osteopathic Medicine, have considered the importance of flexibility, size, and speed in their prototype. As a result, the array can be fabricated as a modular component and integrated into a biohybrid electronic platform.
“While the current iteration of the device is intended to be deployed in a clinical setting by a physician, future improvements in the technology could be incorporated into a patch that a patient could use at home and clinicians could access to the data remotely to monitor their patients,” said Cohen-Karni.
As this sensor array is further developed, the research group will seek to monitor NO levels beyond seven days in order to capture its role in healing and preventing scarring in chronic and delayed wound healing.
THE FLEXIBLE DEVICE WILL BE ABLE TO CONFORM TO A WOUND’S TOPOLOGY TO ACCURATELY MEASURE NITRIC OXIDE LEVELS.

Proximity effect shows potential for more efficient electronics
The newly discovered method of layering nonferroelectric and ferroelectric materials could be applied to semiconductor and optoelectronic devices.
Ferroelectric proximity effect, when a non-ferroelectric material starts behaving like a ferroelectric material at the boundary where the two materials meet, has the potential to improve the components used in many technological applications. Materials that are ferroelectric have a spontaneous electric polarization that can be reversed by the application of an external electric field, and as such they are useful in data storage and wireless communication operations.
In a recent study published in Nature, Pennsylvania State University and Carnegie Mellon University researchers analyzed layered structures of nonferroelectric materials (AlN and ZnO) and ferroelectric materials (Al1 x BxN, Al1 x Sc xN, and Zn1 xMgxO) in a variety of configurations. Using various testing methods, they confirmed that both layers could switch their electrical polarization, inducing ferroelectricity into pure zinc oxide by stacking it with a ferroelectric material, such as magnesium-substituted zinc oxide thin films. The switching starts at the boundary in the ferroelectric layer and spreads to the non-ferroelectric layer, making it easier for the whole structure to change its polarization.
Contributors to the research from the CMU department of materials science and engineering included Department Head and Teddy and Wilton Hawkins Distinguished Professor Elizabeth Dickey, Professor Ismaila Dabo and Special Research Faculty Sebastian Calderon. This team also contributed to other recently reported research that provided insight into the switching mechanisms of AlN-based ferroelectrics.
As the amount of energy consumed by computing devices continues to grow and more efficient technologies are explored, this discovery is notable

because it allows certain materials to become ferroelectric without changing their chemical makeup, which tends to degrade useful properties. The research also indicates that the switching layer can occupy as little as 3% of the total heterostructure volume, allowing the most-desirable material properties to represent the majority.
“The findings open up new possibilities for integrating a wide variety of ferroelectric materials into nextgeneration semiconductor and optoelectronic devices,” said Dickey.
Understanding and controlling ferroelectric proximity effects is crucial for developing advanced nanoelectronic devices and exploring new avenues in materials science. One option to reduce energy consumption is changing the way processors talk to each other using light instead of electronics, noted Jon-Paul Maria, professor of materials science and engineering at Penn State and lead author of the study.
“This could mean that other enabling materials are already known, and exciting functional properties like ferroelectric switching just need unlocking using this proximity effect,” Maria said.
In addition to team members from Carnegie Mellon and Penn State, researchers from University of Pennsylvania and Oak Ridge National Laboratory also contributed to this research.




“The findings open up new possibilities for integrating a wide variety of ferroelectric materials into next-generation semiconductor and optoelectronic devices.”
- Elizabeth Dickey, Department Head and Teddy and Wilton Hawkins Distinguished Professor, CMU Department of Materials Science
and Engineering

Source: Sebastian Calderon, CMU
Schematics illustrating electricfield-driven polarization reversal in AlN—a non-ferroelectric polar material (top panel)— induced by stacking it with one or more adjacent ferroelectric materials (bottom panel). The inset images show experimental differentiated differential phase contrast (dDPC) STEM images collected for a single-layer AlN (left panel) and for AlScN and AlN in an AlN/AlScN bilayer (right panel).
MSE researchers deliver AI solutions to U.S. Army additive manufacturing programs

“Additive manufacturing is ripe for the application of AI, and Carnegie Mellon is deeply immersed in the AI that can deliver real solutions.”
-Jack Beuth, Faculty Co-Director, Next Manufacturing Center
In 2020, when Carnegie Mellon University entered into a five-year cooperative agreement with the U.S. Army Combat Capabilities Development Command’s Army Research Laboratory (ARL), their mission was to develop artificial intelligence approaches to enable the use of metal additive manufacturing (AM) in varied locations by a wide range of users.
Since then, more than 45 research projects have been undertaken by Carnegie Mellon researchers from across the university. Nearly all of the projects included multiple investigators, and most teams were interdisciplinary, bringing together experts from the Robotics Institute, School of Computer Science, and College of Engineering, including the Departments of Chemical, Mechanical, Electrical and Computer Engineering, and Materials Science and Engineering.
Last fall, the final AI Enabled Additive Manufacturing Workshop and Demonstrations were held on the CMU campus and at Mill 19 to showcase results of the most recent research. The showcased projects delivered more than research results; they produced software products and techniques that were demonstrated to the Army on a yearly basis.
Given the multiple parameters and vast number of combinations of materials, designs, and processes that can be used to optimize 3D printing, the program focused on the application of artificial intelligence and machine learning techniques and tools to nearly every

aspect of additive manufacturing.
“AM is ripe for the application of AI, and Carnegie Mellon is deeply immersed in the AI that can deliver real solutions,” said Jack Beuth. Beuth, the project’s principal investigator, co-director of Carnegie Mellon’s Next Manufacturing Center, and professor of mechanical engineering, also discussed project research he led on multi-sensor process monitoring, where data is acquired simultaneously from sensors such as high-speed cameras, infrared cameras, acoustic microphones, and photodiodes. AI algorithms are used to relate these data streams to enhance part quality. Laboratory-based demonstrations of these capabilities were given to the visiting ARL team.
Other demonstrations of software, hardware, methods, and techniques were presented throughout the two-day meeting.
Tony Rollett, co-director of Carnegie Mellon’s Next Manufacturing Center and professor of materials science and engineering, demonstrated software
that is used to compile and consolidate large multimodal data sets. By addressing data storage capacity; file naming conventions; and data retrieval standards, researchers will have better access to data needed for applying machine learning tools to advancing AM technology.
Mohadeseh Taheri-Mousavi, who is designing compositional alloys for powder bed fusion, demonstrated how combining Integrated Computational Materials Engineering (ICME), machine learning, and inverse design techniques can enable the discovery of target combinations of material properties. The assistant professor of materials science and engineering will continue that work to create advanced additively manufactured structural alloys that can sustain extreme environments with collaborators from the chemical engineering in research that is being supported by the Naval Nuclear Laboratory.
The extensive development of AI-based software for AM was reinforced by the ARL-funded acquisition of AM equipment, particularly of machines with open control systems that allow the exploration of manufacturing approaches beyond what current industry-targeted machines allow. These machines, coupled with existing industry standard machines on campus and at Mill 19 are allowing CMU Next Manufacturing Center researchers to apply AI methods to future processing scenarios while relating them to machines currently used in AM labs across the country. This full range of 3D printing equipment makes the Carnegie Mellon AM program one of the most comprehensive and wellequipped in the country.
Support for the many research projects gave students at all levels—undergraduates, master’s, and doctoral students—outstanding experience that prepares them for careers in the field.
“Carnegie Mellon graduates are in high demand for AM jobs in industry, government, and academia thanks to the training and experience they receive here,” said Beuth, who explained that nearly all graduate engineering students are also being trained in AI and machine learning, which further enhances their career prospects.
The ARL program also helped to forge a working relationship with Barnes Global Advisors, a leading firm in advanced manufacturing consulting and training. The group is eager to continue partnering with the university to create training programs that will further advance the adoption of AI-enabled additive manufacturing and expand its usability to more users at varying skill levels.



A design to balance strength and cost Printable aluminum alloy advancements
Aluminum alloys are widely used in transportation applications because of their high strength-to-weight ratio, as well as their affordability. However, challenges arise when using them in extreme high strength and high temperature applications, particularly in components such as pistons of combustion engines, fan blades of jet engines, and vacuum pumps. At elevated temperatures, few aluminum alloys can block dislocation movements effectively, which controls the strength. Moreover, few of the designs have considered costs and sustainability metrics in the design, which is essential for high-demand industries. Titanium alloys, such as Ti-64, which are often used in fan blades, are not only heavier and not machinable, but also nearly twice as expensive.
Additive manufacturing (AM) is rapidly evolving and providing new

pathways for designing innovative alloys. A recent study from Carnegie Mellon University and Massachusetts Institute of Technology (MIT) utilized computational simulations and optimization techniques to identify a new aluminum alloy system that balances strength and cost. The study proposes Al-Ni-Er-Zr-Y (aluminum, nickel, erbium, zirconium, and yttrium) as a class of aluminum alloy that the cost/strength trade-off can be tailored to achieve 95% strength of a benchmark printable Al alloy with 15% anticipated net cost savings. Using the same framework, another room-temperature design was generated that matched the strength of benchmark alloys while achieving 80% cost savings.
“The development of these aluminum alloys has the potential to make a significant impact in the automotive industry because of the

high demand for high performance alloys with a more sustainable and lower cost materials,” said assistant professor Mohadeseh Taheri-Mousavi, who contributed to this research along with current doctoral student Benjamin Glaser.
Using high-throughput calculated phase diagram (CALPHAD)-based integrated computational materials engineering (ICME) simulations together with machine learning techniques, they rapidly explored composition-process–structure–property relationships and identified alloys that will surpass benchmark properties. Laser-based AM offers a higher cooling rate, allowing aluminum alloys to be solidified rapidly and creating new microstructural features. This study exploits metastable phases that precipitates only in rapid solidification to improve the strength.
A path to higher as-built ductility

Most aluminum alloys made through additive manufacturing (AM) have very limited as-built ductility, which may lead to adoption of more expensive, heavier alternative materials in applications such as automotive and aerospace parts. Limited ductility in AM alloys can originate from specific AM processing defects or microstructural features. With all efforts in optimization of processing defects, still the microstructural effects have limited the as-built ductility of high strength Al alloys.
Researchers in the materials science and engineering department at Carnegie Mellon University have developed a new class of aluminum alloy (Al-Ni-Er-Zr) with an optimized composition that enhances asbuilt ductility from from 0.9% to 19%, while minimizing the effects on the alloy’s strength. Their recently published paper in npj Advanced Manufacturing shares the findings from the calculation of phase diagrams (CALPHAD)based integrated computational materials engineering (ICME) simulations and the validation of the results.
Through experimental characterization, the research team systematically studied the embrittlement phases of existing alloys with low ductility and high strength in order to understand what causes them to break so quickly.
“Once we found the origin of the fracture, we were able to perform a simulation to understand how we can optimize the elements in a way that maximized strength and improved ductility,” said assistant
professor Mohadeseh TaheriMousavi, who supported this research along with her current doctoral student Zhaoxuan Ge.
High as-built ductility is important for those manufacturing techniques in which post heat treatment of prints are challenging, such as welding. These processes are key to structural integrity in applications such as automobiles and aircraft.
“With improved ductility, strength, and temperature tolerance, aluminum alloys could replace heavier, more expensive titanium and nickel alloys and steels,” said Taheri-Mousavi.
As-built ductility, which does not include any subsequent post-processing techniques, is important for larger scale printing in AM, because a material cannot tolerate the residual stress encountered during printing if it has low ductility. As such, the new formula has potential to be used on larger components of automotive and aerospace vehicle parts.
The fracture surface of the designed high-ductility alloy as shown through SEM characterization. Compared to the fractography of the benchmark alloy, the designed alloy exhibits a greater number and larger size of dimples.


Modeling for better thermal management


Keeping electronic devices cool is important when considering both their function and durability, as the temperature influences material properties and energy flow. The temperature of “hot spots” that can be detected impacts the performance of various technologies from smartphones to electric vehicles. The ability for devices to work at faster speeds has stalled in recent years because adding more power to them has resulted in overheating.
When examining heat transport at the nanoscale level, challenges arise because heat behaves fundamentally differently at tiny scales and traditional heat-flow models are inadequate to predict behavior.
Professor Ismaila Dabo and his collaborators, including Albert Beardo, assistant professor at Universitat Autònoma de Barcelona, examined the two competing theories - ballistic flow and hydrodynamic flow - by comparing computational predictions against real-world experiments. In the ballistic framework, heat behaves unpredictably with individual particles bouncing around erratically. In the hydrodynamic framework, heat is treated more like a flowing fluid with particles moving in concert. While these models are conflicting in their nature, the research analysis
In the ballistic framework, individual particles bounce around erratically. In the hydrodynamic framework, particles flow in concert.
published in npj computational materials advocates for a combination of the theories in order to better understand heat flow in nanoscale systems.
“In order to build faster and more sustainable technologies, we need to develop a better way of approaching thermal management,” said Dabo.
One of the challenges is that it is difficult to predict or measure how vibrational energy moves in 3D at very small scales.
“Our recent analysis shows that the two leading theories for predicting heat transport in nanodevices each capture important physics, and there is potential to use the benefits of each of the existing frameworks,” said doctoral candidate Tara Sabet, who contributed to the study.
In future research into how these models can be better incorporated together, comparisons of the frameworks through detailed simulations and quantum methods could be useful in creating better theories.
“By combining insights from both approaches, we’re working toward better tools to manage heat, which could help overcome current performance limitations caused by overheating,” said Sabet.
Ballistic flow
Hydrodynamic flow
A new class of self-healing polymer hybrid materials
“Self-healing” materials have the potential to enable longerlasting, more durable products and devices. The specially designed substances can automatically repair damage to themselves, either completely or partially, without human intervention, similar to how human skin heals a cut.
Researchers at Carnegie Mellon University have created a new class of polymer hybrid material featuring “integrated self-healing.” By admixing a flexible, linear copolymer with rigid brush particles, the team, led by professors Michael Bockstaller and Krzysztof Matyjaszewski, demonstrated mechanically strong hybrid materials in which two mechanisms, dubbed ‘intrinsic’ and ‘extrinsic’ self-healing, work together to facilitate structural recovery after damage.
“This approach enables the fabrication of high modulus, or stiffer, self-healing polymers by derivatizing a chemistry that is already in widespread use, rather than developing an entirely new chemistry for which no applications yet exist,” said Bockstaller. “We hope that such a benefit could accelerate the adoption of this approach.”
capillary network structure similar to biological systems, that allows for transport of the flexible polymer.
Polymers are often used in applications in concert with other materials or material systems, and in these applications device failure is often linked to the breakdown of the polymer component. In such use scenarios, polymers have a critical performance limiting role. By combining precision polymer chemistry, such as atomtransfer radical polymerization, with bio-inspired methods of self-assembly, this innovative approach demonstrates a scalable way to produce multifunctional materials that do not lose their special properties, even after being damaged multiple times.

Using transmission electron microscopy (TEM) tools in the Materials Characterization Facility, Hanshu Wu and Yuqi Zhao, two graduate students who equally contributed to this work, observed the formation of a hierarchical microstructure in which the flexible polymer additive concentrates within channel-like spaces between brush particles. This created a
The combination of mechanical strength and self-healing in this newly developed material is especially promising for the design of long-lasting, highperformance polymers that could be used in a variety of applications such as coatings, electronics, and packaging.
“We believe that we have just been scratching the surface of performance enhancements that might be possible using this approach,” notes Bockstaller.
Future research will focus on expanding the range of materials to which the approach can be applied, to further increase the modulus of self-healing materials, and to explore strategies that enable the acceleration of self-healing processes.

Image: 3D microstructure before and after grain growth at 800 °C.

New growth perspectives
From metals to ceramics to electronic materials, microstructure and grain size are important to the strength and durability of many devices and tools used in everyday life. Abnormal grain growth (AGG) occurs when a few grains in a material grow much larger than the rest, and has significant effects on the properties and performance of materials. AGG can either improve or harm materials’ properties depending on the application. Some manufacturers will add particles to materials to try to prevent AGG in order to achieve a uniform grain structure that can optimize performance in products such as engine parts and electronics.
Scientists don’t fully understand why AGG occurs, but advancements in microscopy technology have enabled researchers to challenge long-held theories. Associate professor of materials science and engineering Amanda Krause and her research group are among those studying how to better predict how processing methods impact a material’s structure.
Recently published work investigates AGG using 3D X-ray imaging of high-purity nickel heated to 800°C. Their findings in this study have disproved some existing theories, finding that initial grain size and a grain’s curvature are not connected to AGG. These theories have not been tested before because typically a material has to be polished or destroyed prior to imaging, preventing the same microstructure from being viewed at different times in the
process; however, this study took a different approach.
“The technique that we used allows us to image the initial microstructure in 3D prior to the abnormal growth without destroying it. We can then look at it again after growth,” said Krause.
Energy levels at the grain boundaries (i.e., interfaces between grains) also did not have a significant impact on causing AGG. The results instead suggest that specific grain boundary structures, such as asymmetric tilt boundaries, could trigger abnormal growth.
“The results of this research are guiding us in the right direction,” said Krause, who is eager to use these findings in future studies.
Additional forthcoming research will examine AGG in ceramics, looking at pores in samples as the impetus for growth to occur.
While the initial condition cannot be studied in this instance due to technical constraints, the observations of the grains over time have provided new insight into what sustains growth.
“The growth at a constant speed that was observed in our recent work points us to a hypothesis about why abnormal grain growth is occurring,” said Krause.
Continued examination of these growth patterns will hopefully guide new theories that will improve the lifespan of technological devices in the future.
MSE graduate students Yi Wang, Zipeng Xu, Vivekanand Muralikrishnan, and Daniel DeLellis have contributed to this research.




FRESH bioprinting brings vascularized tissue one step closer
Using their novel Freeform Reversible Embedding of Suspended Hydrogels (FRESH) 3D bioprinting technique, which allows for the printing of soft living cells and tissues, the Feinberg lab has built a first-of-its-kind microphysiologic system, or tissue model, entirely out of collagen. This advancement expands the capabilities of how researchers can study disease and build tissues for therapy, such as Type 1 diabetes.
Traditionally, tiny models of human tissue that mimic human physiology, known as microfluidics, organ-onchip, or microphysiologic systems, have been made using synthetic materials such as silicone rubber or
we’re able to engineer very tiny features that are almost capillary scale. By recreating this complex architecture, it allows us to build tissues that mimic different organ and disease types.”
This technology is currently being commercialized by FluidForm Bio, a Carnegie Mellon University spinout company where co-author Dr. Andrew Hudson and his team have already demonstrated in an animal model that they can cure Type 1 diabetes in-vivo. FluidForm Bio plans to start clinical trials in human patients in the next few years.
“It is paramount for everyone to understand the
“Going forward, the question is not, can we build it? It’s more of, what do we build?”
-Adam Feinberg, professor, biomedical engineering and materials science and engineering
plastics, because that was the only way researchers could build these devices. Because these materials aren’t native to the body, they cannot fully recreate the normal biology, limiting their use and application.
“Now, we can build microfluidic systems in the Petri dish entirely out of collagen, cells, and other proteins, with unprecedented structural resolution and fidelity,” explained Adam Feinberg, professor of biomedical engineering and materials science and engineering. “Most importantly, these models are fully biologic, which means cells function better.”
In recent research published in Science Advances, the group demonstrated the use of this FRESH bioprinting advancement, building more complex vascularized tissues out of fully biologic materials, to create a pancreatic-like tissue that could potentially be used in the future to treat Type 1 diabetes.
“This advance in FRESH bioprinting builds off of the research we published in Science in 2019, by improving the resolution and quality to create little fluidic channels that are like blood vessels down to about 100-micron diameter,” noted Feinberg. “Just as a frame of reference, the human hair is roughly 100 microns in diameter, so


Pictured above: A full-size 3D bioprinted human heart model created with FRESH technique.
importance of team-based science in developing these technologies and the value that varied expertise, ranging from biology to materials science, brings both to the project, and our impact on society,” elaborated Feinberg.
“Going forward, the question is not, can we build it? It’s more of, what do we build? The work we’re doing today is taking this advanced fabrication capability and combining it with computational modeling and machine learning, so that we can hopefully better understand what we need to print. We want the tissue to better mimic the disease of interest or ultimately, have the right function, so when we implant it in the body as a therapy, it’ll do exactly what we want.”
Feinberg and his collaborators are committed to releasing open-source designs and other technologies that allow for broad adoption within the research community. “What we’re hoping is that very quickly, almost immediately, other labs in the world will be able to adopt and use this capability to expand it to other disease and tissue areas,” Feinberg said.
Upgrading direct air capture


Instead of reinventing the wheel with their latest project, researchers Paul Salvador and Mohammad Islam are making an existing system more efficient, affordable, and effective. The “wheel,” in this scenario, is direct air capture (DAC), a technique that works exactly as it sounds by taking carbon dioxide out of the atmosphere and either storing it or repurposing it by making other types of materials.
“In this case, decarbonization means removing the impact of using materials that produce carbon dioxide as opposed to eliminating its use,” said Salvador, a professor of materials science and engineering who’s also the director of the Energy, Science, Technology and Policy Program at Carnegie Mellon.
Thanks to support from a Scott Institute seed grant, Salvador and Islam hope to resolve a key issue with current DAC technologies: They don’t capture enough greenhouse gas (GHG) emissions to justify the steep cost.
“The sorbents, which absorb carbon dioxide, tend to be the largest cost and need to be improved,” said Salvador.
In a perfect world, DAC works quickly and efficiently, with aerogels acting like sponges to capture and release carbon dioxide. However, current systems spend too much time desorbing the carbon dioxide, curtailing the amount of GHG emissions taken from the atmosphere. Salvador and Islam propose using aerogel sorbents made of metalorganic frameworks (MOFs) as a way to improve the desorption rate of captured CO2.
“The integration of MOFs into carbon nanotube networks reduces the size of MOF crystals, enhancing their CO2 capturing abilities,” said Islam, a professor of materials science and engineering. “The carbon nanotube network can rapidly heat these smaller MOF crystals, facilitating the quick release of CO2 from the MOF crystals.”
The sooner that captured CO2 is released, the sooner the DAC process starts over, leading to more CO2 capture in a shorter time frame.
“Cost-benefit analysis is something that we always have to do when evaluating technology for commercial use,” said Islam. “The system that we are proposing would allow us to capture carbon at a cost that makes it a financially viable option.”
In addition to supporting GHG emissions goals, Salvador and Islam are pleased that this project has engaged innovative students from undergraduate, master’s, and doctoral programs. This project also marks the first time that both faculty have focused on carbon capture as a research topic.
By making DAC a faster and cheaper process, Salvador and Islam’s research could contribute to a larger initiative Carbon Negative Shot™, which aims to find alternative carbon sources and make it available at gigatonne scale for less than $100 a tonne.

CISR forges on after 40 years
On May 9, 2025, alumni, students, faculty and staff affiliated with the Center for Iron and Steelmaking Research (CISR) gathered at Mill 19 to celebrate the 40th anniversary of the Center.
The CISR has made significant contributions to the iron and steel industries through collaborative efforts between corporate partners and CMU faculty and students. CISR was established in 1985 as an Industry/University Cooperative Research Center (I/UCRC) with support from 11 companies, the National Science Foundation (NSF), and Carnegie Mellon University. The late professor Richard Fruehan led the effort from Carnegie Mellon as the center launched its initial research endeavors.
Read the full story on the history of the CISR on pages 50-51 the College of Engineering Fall Magazine or at engineering.cmu.edu/cisr.

The Center for Iron and Steelmaking Research (CISR) has made significant contributions to the iron and steel industries through collaborative efforts between corporate partners and CMU faculty and students.


“The CISR put Carnegie Mellon on the map as the number one steel making research university in the world.”
- Alan Cramb, former CISR Director

“Working with the center that was an integral part of my graduate experience has been rewarding in many ways, none more so than working with students as they make scientific discoveries and become independent researchers.”
-Bryan
Webler M.S.’07, Ph.D. ‘08, MSE Professor, CISR Co-Director

“The Center has very deep links with the steel industry through what Dr. (Richard) Fruehan built up, running well-designed, insightful research projects that are useful to industry and having graduates from the center who can enter industry.”
- Chris Pistorius, MSE Professor, CISR Co-Director
“Joining the CISR allowed me to build many steel industry contacts, which in many cases evolved into lasting friendships that opened up career opportunities. The CISR, through its focus on studying steelmaking and casting process fundamentals, has made many significant contributions to improving productivity, efficiency, and quality of these processes.”
-Scott Story M.S.’95, Ph.D.’97
Faculty and Staff Awards and Recognition
1 Amanda Krause was promoted to Associate Professor and is a 2025 recipient of the College of Engineering Dean’s Early Career Fellowship award.
2 Elias Towe received the John Bardeen Award from TMS in recognition of outstanding contributions and leadership in the fields of electronic and functional materials.
3 Anthony Rollett’s article ‘Computer simulation of microstructure development in powder-bed additive manufacturing with crystallographic texture’, has been recognized with IOP’s North America Top Cited Paper Award.
At the TMS Spring Meeting, a symposium was held in honor of Rollett in recognition of the contributions that he has made throughout his career in additive manufacturing.
4 Olexander Isayev has been jointly appointed as a professor in the MSE department. Isayev was named as the Inaugural Carl & Amy Jones Professor of Interdisciplinary Science in October 2024.
5 David Laughlin received the 2025 J. Willard Gibbs Phase Equilibria Award from ASM International for sustained teaching and research on the application of thermodynamics to materials science and engineering, including a textbook and application of the Third law to the proper display of phase diagrams.
6 Noa Marom was promoted to Professor.
7 Mike McHenry and alumnus Paul Ohodnicki (M.S. ‘06, Ph.D. ‘08), along with Kyle Schneider, were honored with at the R&D 100 Awards for their work on Axial Flux Switching Motors, a key technology advancement in the founding of CorePower Magnetics.
8 Greg Rohrer was honored by TMS with the Cyril Stanley Smith Award, in recognition of outstanding contributions to the science and technology of materials structure.
Elizabeth Dickey was named a 2025 Materials Research Society Fellow in recognition of her accomplishments in the use of high-resolution transmission electron microscopy to advance the understanding of nanomaterials, dielectric materials, ferroelectric switching, and high entropy oxides.

9 Marc De Graef was selected by the Microscopy Society of America as the 2025 recipient of the Distinguished Scientist Award in the physical sciences. De Graef also received the 2025 MAS Peter Duncumb Award for Excellence in Microanalysis from the Microanalysis Society.

10 Chris Pistorius will be awarded the Institute of Materials, Minerals & Mining Hadfield Medal for distinguished work in metallurgical practice, process/ product development, metallurgical understanding or design engineering application of steel in December 2025. Earlier this year, he was named as an American Institute of Mining, Metallurgical and Petroleum Engineers (AIME) Honorary Member.
College of Engineering Staff Awards
Several MSE staff were recognized by the College of Engineering this year. Angela Pusateri received the Burritt Education Award, which acknowledges a staff member who is pursuing a degree. Alyssa Bernens, Reed Hoffmier, Andrew Nickischer, and Anthony Talotta were also nominated for awards and Daniel Flaherty (5 years) and Jeanna Pekarcik (20 years) were recognized for service milestones.









Rohrer appointed as University Professor
“My 35 years in MSE have been filled with memorable interactions with brilliant students and colleagues.”
Greg Rohrer, University Professor, Materials Science and Engineering
Greg Rohrer, the W.W. Mullins Professor of Materials Science and Engineering, was one of three Carnegie Mellon University faculty members chosen to receive the title of University Professor in 2025.
University Professors are internationally recognized leaders in their fields, selected for the distinction based on their contributions to education, artistic creativity and/or research. The impact of the work done by University Professors can be seen both within their respective institutions and beyond. The title is meant to reflect the value of their work as the highest designation a faculty member can receive at Carnegie Mellon.
Rohrer joined Carnegie Mellon’s faculty in 1990, and from 2005 to 2021 he was the head of the Department of Materials Science and Engineering.

“Being named a University Professor is a tremendous honor for me,” Rohrer said. “My 35 years in the Department of Materials Science and Engineering have been filled with memorable interactions with brilliant students and colleagues. These interactions have made it possible for me to learn something new every day, and in this profession, that is the most satisfying reward.”
Rohrer is a fellow of the American Ceramic Society and the Materials Research Society. He has authored or co-authored more than 360 publications, and is currently the coordinating editor of the Acta Materialia family of journals.
Dabo receives presidential early career award
Energy sustainability is a pressing global challenge that requires materials that are capable of efficiently converting and storing energy. Using quantum mechanical models and machine learning methods has accelerated the discovery of materials that can be formulated before they are synthesized for use in technology applications.
Professor Ismaila Dabo is developing predictive computational capabilities to identify materials for use in efficient energy systems with a focus on hydrogen generation and utilization. His research efforts have been recognized by President Biden with a Presidential Early Career Award for Scientists and Engineers (PECASE), the highest honor bestowed by the U.S. government on outstanding scientists and engineers early in their careers. Established by President Clinton in 1996, PECASE acknowledges scientists and engineers who show exceptional potential for leadership early in their research careers.
“Receiving this award is an immense honor, for which I thank my supportive family and mentors. Materials modeling is instrumental in making strides toward reliable energy access on the African continent and across the world,” said Dabo.
Dabo joined the department of materials science and engineering faculty in 2024, and will spend fall semesters teaching at CMUAfrica, and spring semesters in Pittsburgh, while also maintaining close contact with program partners in Kigali. This fall, he is teaching the Foundations of Materials Science and Engineering course that will be synchronously available to students studying in Pittsburgh. The connection of his research to both locations stands to make an immense impact


on capacity building and inspire future generations of engineers to pursue work in this discipline.
“Developing sustainable energy is a challenge, particularly in Africa where supply is an issue,” said Dabo. “By creating models to expedite the implementation of new materials, we aim to improve access, reduce carbon emissions, and improve mineral extraction processes.”
Driving innovation beyond the classroom
The intersection of academia and industry is central to Jay Whitacre’s role as a professor in the Departments of Materials Science and Engineering (MSE), Engineering and Public Policy (EPP). In addition to his position at the university, Whitacre is CEO, CTO, and Founder of Stratus Materials, a CMU spin-out that develops and manufactures manganese-rich, cobalt-free cathode active materials (CAMs) for lithium-ion batteries.
The company, funded by Bill Gates-backed venture firm Breakthrough Energy Ventures, was founded in 2022 with the intent to commercialize next generation battery materials

that offer a combination of performance, safety, cost, and environmental impact to leading battery manufacturers and their original equipment manufacturer (OEM) customers.
“I’m enjoying wearing two hats - working with the company and teaching,” said Whitacre. “I think sharing the industry perspective with students gives them an opportunity to observe and gain insights into areas they may be interested in pursuing.”
When he arrived at CMU as a faculty member in 2007, Whitacre had a wealth of experience in studying batteries and the metal oxide materials they rely on. As he was advising one of his doctoral students, Sven Burke, Ph.D ‘22, he encouraged him to study their sensitivity to heating and cooling rates. In 2020, when lab spaces on campus became inaccessible due to the pandemic, Whitacre set up a small laboratory off campus where significant progress was made that brought the concepts to a stage where fundraising could be initiated to launch the business. To date, Stratus has raised $22 million in venture funding and employs 29 team members, including MSE alumni Wei Wu (Ph.D. ‘14) and Jiang Chang (M.S. ‘14), CMU alumni Ardash Dave (Ph.D. ‘22) and Emma Rhem (BA, ‘03), and former staff member, Jared Mitchell.
Stratus makes a stable next generation lithium-rich/ manganese-rich oxide cathode material (LMR) referred to as “LXMO.” Cathode materials are currently a critical bottleneck in the domestic supply chains for advanced battery and electric vehicle production. This year, the company is increasing their capabilities by setting up a pilot line in an East Liberty facility that will process up to 30 tons of material annually.
The company was awarded $2.99 million from the Department of Energy to develop a high-energy-density composite phosphate-based cathode active material called PhosCAM, which combines the high energy density attributes of lithium-rich/manganese-rich materials with the low cost and high safety of phosphate-based materials. The goal of this project is to demonstrate the ability to produce, at meaningful scale, phosCAM material that balances durability and cost. Reeja Jayan, professor of mechanical engineering, is a co-investigator with Whitacre on the grant.
“This scaling will be big enough to make us compelling to the automotive and battery production industries,” Whitacre said. “Our intention is to have partnerships with various large companies along the value chain, including materials producers, battery cell makers, and automotive OEMs.”
OUTREACH
Connecting materials science to classrooms
In June, the Department of Materials Science and Engineering (MSE) hosted ten educators for the ASM Materials Camp® for Teachers. Participants in the program included regional middle and high school teachers, as well as STEM education specialists from the 4-H Program. The heavily project-based course serves as a means to introduce educators to concepts that they can use to teach their own materials related course or to infuse some components into their existing curriculum.
Through participating in hands-on lessons pertaining to metals, ceramics, polymers and composites, teachers are able to transfer these experiences to their own classrooms and give students a better understanding of the connections between materials and their everyday lives. During the week, the educators participated in tutorials in the materials characterization facility, used equipment in the undergraduate materials innovation laboratory, and toured the nanofabrication laboratory.
“The ASM camp really opened my mind into a practical use of chemistry,” said Jenna Warren, a teacher at Nazareth Prep High School who participated in the program. “The camp was definitely the best use of my summer time as a teacher and I plan on using what I learned to get students interested in materials science careers.”
The course was led by ASM Master Teachers, Justin Sickles and Kelly Calvelage, teachers who have successfully implemented components of the program into their own classrooms. These teachers who previously participated in the program go through additional training in order to become certified to lead the camp.
“I continue to teach these workshops because the materials science content is so interesting, engaging, and practical,” says Sickles, who is a high school teacher in the West Mifflin School District. “I really enjoy helping the teacher attendees learn about the amazing connections that materials science has to every content area.”
Organized by the ASM Foundation, the camp is free of charge for participants. Since 2002, thousands of teachers have taken part in this hands-on opportunity, and as a result students across the country have discovered the importance of materials science through engineering, technology, or science courses in their school. The Carnegie Mellon College of Engineering supported this event to offset the costs associated with the program.
“We were pleased to host this group, as they are integral partners in inspiring the next generation of materials scientists and engineers,” said MSE department chair, Beth Dickey. “We hope that students will gain a better understanding of the versatility that an education in MSE offers through the connections these teachers can now provide.”



STUDENTS
Spirit of discovery motivates Rales Fellows

Materials science and engineering master’s degree students Cameron Drewery and Nisha Shah are among the inaugural cohort of Carnegie Mellon University Rales Fellows. Launched in 2023, the program is dedicated to cultivating the next generation of science, technology, engineering and math (STEM) leaders while also increasing access to graduate-level education.
Drewery aspires to use 3D printing for disaster relief
As a Hurricane Katrina survivor originally from Baton Rouge, Louisiana, Drewery recognized an opportunity to use her knowledge and future research in additive manufacturing to help families in coastal areas that are repeatedly subjected to heavy storms.
“I’ll still see roofs that have tarps on them from hurricanes that happened years and years ago,” she said.
While earning her bachelor’s degree in mechanical engineering from Howard University, Drewery spent a summer as an undergraduate researcher at Florida International University that solidified her interest in applications for the industrial process.
She used a digital light processing 3D printer that combined resin with tantalum carbide, a ceramic compound, to create a small rocket nozzle. Even though it was about half the size of a person’s index finger and it took all day to print, Drewery said it inspired her to dig deeper.
“If we’re able to 3D print ceramics using a variety of additive manufacturing methods, then we can
print very complex geometries that could be manufactured,” Drewery said.
New innovations are already using additive manufacturing to 3D print houses using concrete but have not yet been applied to portions of existing buildings, she noted.
“Why not bring that to the communities that are being battered over and over and over by these storms?” Drewery said. “That way these families don’t have to start over every time a storm hits.”
Structural components could be recreated to replace shingles or reinforce roofs, she said.
“I want to know if we can use ceramics and metals to print composite materials on exteriors of structures in hurricane-bound or tornado-bound areas to protect from projectiles and debris in high-wind environments or from flooding damaged homes,” she said. “Maybe we can strengthen these homes or improve the overall structural integrity of them.”
When searching for ways to contribute to future innovations by gaining more focused experience in the field, Drewery realized Carnegie Mellon is one of the few universities with a master’s degree program in additive manufacturing.
“With climate change, these storms are only getting more intense and we’re seeing a rise in newly constructed homes, but they’re all being constructed out of the same things they were 20 years ago,” she said. “The possibilities are endless. If I can be a pioneer in the industry, that’s something that I would love to do.”
After her participation in the fourth cohort of the Karsh STEM Scholars at
Howard, Drewery said she appreciated the similarities between that program and the Rales Fellows Program, including mentoring and advising.
Combining those specific resources with the others available at Carnegie Mellon, “makes it a luxury to be a student,” she said. “There’s no financial barrier, there’s no administrative barrier, no academic barrier.
Everything you need is right here.”
Shah hopes to make better batteries more sustainable
After graduating from the University of Pennsylvania with an undergraduate degree in materials science, Shah found out about the Rales Fellows Program when she was applying for jobs and master’s degree programs at the same time.
Shah first developed her interest in materials science taking chemistry courses, wanting to apply what she was learning to decarbonization technologies, which include renewable energy systems and sustainable transportation.
“I found myself most interested in working at the cell level of batteries,” she said. “If you think of a Tesla (electric car), you’ve got to pack a bunch of really small, cylindrical cells all stacked up in series, in parallel, and they build up a high-powered battery pack. Each of the individual cells are made of many different materials in contact with each other in varying forms and geometries, so the cells themselves have really interesting materials challenges.”
During her undergraduate degree, she interned at Vermont-based electric

aviation startup Beta Technologies. Combining that experience with her introductory electrochemistry and renewable energy materials courses, Shah said the field came more into focus for her.
“I want to apply my engineering background to a career developing higher-performance battery cells,” she said. “I saw firsthand the efforts exerted by my colleagues to design around the safety and performance limitations of externally sourced cells. The introductory electrochemistry and renewable energy materials courses I’ve taken have reinforced this desire.”
Now, she’s doing research alongside MSE professor Jay Whitacre, who is also jointly appointed in the Engineering and Public Policy program and is affiliated with the Wilton E. Scott Institute for Energy Innovation.
The lab works on materials and energy policy for electrochemical energy storage and generation. Specifically, Shah focuses on cobalt-free cathode materials in order to make more environmentally sustainable batteries instead of relying on the mined metal, she said.
“Taking cobalt out of the battery material while still trying to maintain cost and the same sort of performance characteristics are really important for battery development,” Shah said. “Batteries have really interesting materials challenges, because they are a stack of several different materials where all their transport and charge mechanisms interplay.”
“I want what I do to have an impact on others or the climate in order to keep my motivation going,” she said.
Drewery graduated in May and accepted a position as an Additive Manufacturing Engineer at Nikon AM Synergy Inc. Shah will join the CMU MSE Ph.D. program in January. Department chair Beth Dickey is set to serve on the Rales Fellows Steering committee.

Nisha Shah
Cameron Drewery

Students compete for EnergyTech University Prize
Batteries power devices that are essential to day-to-day life, from phones to computers to cars. The elements that make up batteries depend on performance needs, and often include “critical minerals,” which are economically and strategically important to the United States, as determined by the United States Geological Survey. Because there is a high demand for these minerals and no convenient substitutes, recycling batteries that have reached end of life has become a means of gathering them for reuse.
A team of two materials science and engineering doctoral students from CMU was selected as a finalist for the 2025 Energy Technology University Prize (EnergyTech UP) organized by the Department of Energy (DOE).
Jeremy Drew and Andrew Timmins reviewed a list of technologies that had been developed at DOE National Laboratories, but had yet to be commercialized. After analyzing the available projects, they chose to pursue a cathode recycling technology in order to advance the Lithium-Ion Battery supply chain.
“When batteries are essentially near their end of their life, companies will
shred them and create ‘black mass,’ which is essentially all of the useful materials in a battery,” said Timmins. “The idea of this technology is that you can take this black mass and, using an electrochemical process, leech out the materials that are of interest and use them in new battery development.”
Through the project, Drew and Timmins assessed the market potential of this technology and created a business plan for commercialization. The evaluation of their plan then went on to a regional final that was hosted by the Scott Institute for Energy Innovation.
Their business plan assessed the market for potential customers and competitors, analyzed the impact on the energy industry, and addressed potential challenges that would need to be overcome. One such challenge is that different batteries have different compositions of elements, so values of the black mass could fluctuate, creating an impact on the business’s revenue. Another challenge they addressed in their pitch was the forecasts related to the supply and demand of batteries, which vary by source and also are subject to price instability that the market has
witnessed in recent years.
“In our economic justification we have to take into account a best and worst case,” said Drew. “But it’s also one of the arguments we make of the advantages of having a recycled battery component as opposed to fresh extraction when these shifts happen.”
Creating a pitch for the Prize has given the both students a chance to go beyond their work in the classroom and lab to understand the entrepreneurial side of materials science.
“There’s so many ways in which this has been different from research,” said Timmins. “We have had to make so many approximations and estimates with limited data and try to gain a better understanding of process costs, so it’s a very new skillset to develop in some ways.”
As finalists, Drew and Timmins were awarded $5000 and were invited to attend the National Pitch Event this summer at the Colorado School of Mines, where they delivered their final pitches to a panel of industry stakeholders and DOE Office of Technology Commercialization leadership.
Unleashing advancements in animal care
Kara Mathias has a big place in her heart for animals. Even as a busy student athlete on the cross country and track teams at Carnegie Mellon, she has made time to care for others’ pets and train a service dog. Her interest spans into her research and career goals, as she is hopeful to explore how biomedical interventions could be applied to animals.
Mathias, a junior majoring in materials science and engineering and biomedical engineering, was selected as a recipient of the Dr. Mete Akin Endowed Fund for Advancement of Pre-Med Education last year. The award recognizes a CMU student who is pursuing a pre-med academic track in honor of Dr. Mete Akin, DC ‘02, who passed away in 2017. An economics major, Dr. Akin recognized that many diverse backgrounds could lead to a medical career. The fund provides financial support for students from any college or program for travel expenses, research projects, or other expenses related to a research or study abroad project.
Through completing internships at both Johns Hopkins and University of Illinois Urbana-Champaign while she was in high school, Mathias was able to gain exposure to the intersection of design, biology, and engineering, which propelled her interest in attending Carnegie Mellon.
“The programs at Carnegie Mellon are unique, and a big draw was being able to complete a dual degree in materials science and biomedical engineering,” she said. “Seeing the advancements that can be made using these disciplines, the curious and driven nature of the students, and the opportunities for start-ups here really drew me in.”
Mathias has aspirations of going on to earn a Doctor of Veterinary Medicine degree and continuing her research efforts in the future.
“I want to be able to combine animal science with biomedical engineering because I think it is an avenue to advance animal medicine which is commonly overlooked,” she said.
She has continued to get hands-on experience, having completed an internship at a university veterinary hospital oncology clinical trials lab. She had the opportunity to track cancer cell lines and cell cultures, conduct assays with cell lines to see how they would react to trial drugs, and image cancer cells to monitor their growth.
Through the Mete Akin award, Mathias plans to continue her research and travel to conferences where she can share her work.

Student awards
1 A team of MSE students - Phylicia Ma, Julea Farchione, Mable Dong, Allison Silva, and Jessica Shi - earned Covestro’s Most Innovative award for being creative and novel in approach or execution at TechSpark’s Engineering Exposition. Their project, “3D Printing Pickleball Paddles of the Future” leverages 3D printing to create sustainable, high-performance paddles that meet USA Pickleball standards. This project highlights the potential of 3D printing to revolutionize sports equipment with eco-friendly, cost-effective solutions tailored for competitive gameplay.
Read more about their project on pages 58-59 of the Fall College of Engineering Magazine!
2 Junwon Seo placed second at the University-wide Three Minute Thesis (3MT) Competition, presenting on, “Additive Manufacturing of Metallic Components - We Bake Rocket Engines!” Scan the QR Code to watch Junwon’s presentation.
6 Pooja Maurya won the student poster competition at ASTM ICAM (International Conference on Advanced Manufacturing) for “Unsupervised Computer Vision for Carbide Detection.”
Undergraduate students Eileen Hung, Phylicia Ma, and Jessica Shi, and graduate student Achuth Chandrasekhar represented Carnegie Mellon in the TMS Materials Bowl competition at the organization’s annual meeting.
Inkyu Lee was recognized with the Best Poster Award at the 10th International Winter School on Bioelectronics held in Austria.

3 Daniel Ranke, earned first place at the Graduate Student Seminar for his presentation on “Photovoltaics for volumetric optical neural modulation.”
4 Students earned first place honors in both graduate and undergraduate research presentations at the AISTech conference - Rafaela Rapalo (Graduate Poster Contest) and Eileen Hung (Undergraduate Project Presentation Contest)
5 Katie Eisenman was selected as the first place winner of the 2025 George Washington Prize. The award is given annually in recognition of academic excellence, commitment to service, and leadership. (Eisenman pictured at left center)
Eileen Hung and Tracey Wan were named as a National Science Foundation (NSF) Graduate Research Fellow. The NSF Graduate Research Fellowship Program aims to ensure the quality, vitality, and strength of the scientific and engineering workforce of the United States, and provides three years of financial support to recipients. Hung will attend Massachusetts Institute of Technology and Wan will attend Northwestern University.
Ellen Angwin was a member of the inaugural cohort of PITA (Pennsylvania Infrastructure Technology Alliance) Fellows. Awarded to eight students in the College of Engineering, fellows received a stipend, participated in a mentorship program, conducted research alongside faculty whose work is funded by PITA, and participated in monthly professional development events.
Sarah Birchall was a recipient of an NSF grant to attend the PowderMet and Additive Manufacturing with Powder Metallurgy conferences, where she won a Poster of Merit award for her presentation of “Characterizing Flowability of Water Atomized Powders for Laser Powder Bed Fusion Additive Manufacturing.”
Congratulations to the Graduate Students who received College and Departmental Fellowships this year:
• Ece Gunay, Neil and Jo Bushnell Fellowship in Engineering
• Grant Kenny, Presidential Fellowship in the College of Engineering
• Hantian Liu, ATK-Nick G. Vlahakis Graduate Fellowship
• Matthew J. Melfi, Presidential Fellowship in the College of Engineering
• Haoran Ni, Richard King Mellon Foundation Presidential Fellowship in Energy
• Daniel Ranke, Neil and Jo Bushnell Fellowship in Engineering
• Vijay Vallurupalli, Richard King Mellon Foundation Presidential Fellowship in Energy
• Milly Yi, Al and Denise Murray Endowed Graduate Fellowship
• Greg Wong, Paxton Endowed Graduate Fellowship








Krivobok-Brooks Awards for Microscopy
Each year, the Department of Materials Science and Engineering at CMU gives the Krivobok-Brooks Awards for Microscopy at the undergraduate and graduate levels. The Awards recognize students who have displayed the greatest evidence of excellence in the art of microscopy, and entries are judged based on technical achievement, scientific significance, and aesthetic value.
This year’s winners were “An Adventure in Eutectics” by Katie Eisenman (undergraduate award - top image) and “Crystalline Mosaic” by Charles Evans (graduate award - bottom image).
Celebrating the class of 2025
On May 10, 2025, degrees were conferred to our undergraduate, masters, and doctoral students. We are proud of the class of 202425 and look forward to hearing about your successes in the future!
The following students were honored at this year’s MSE diploma ceremony:
William T. Lankford Jr. Memorial Scholarship
Melinda Chen
James W. Kirkpatrick and Jean Kirkpatrick
Keelan Scholarship
Ruoyi (Riley) Zhao
William W. Mullins Undergraduate Award
Tracy Wan
Hubert I. Aaronson Undergraduate Award
Eileen Hung
John H. Perepezko Award
Josiah Shuman
Outstanding Senior Award
Katherine Wu
Award for Research Excellence in the Master’s Program
Hantian Liu
Award for Academic Excellence in the Master’s Program
Viswesh Prakash
The Paxton Award for Best Doctoral
Dissertation
Yuqi Zhao











In Memoriam
Neeha Dev Arun, who finished her Ph.D. with Professor Adam Feinberg in 2024, passed away in May 2025. Neeha had been struggling with major health issues during the end of her Ph.D., which prevented her from joining us at this year’s diploma ceremony. The department has sent condolences to the family and plans to honor her memory at the 2026 diploma ceremony.


ALUMNI HIGHLIGHTS
Powering up through problem solving
“At heart, I’m still a materials scientist. I coach my team to solve problems with the same curiosity and discipline that shaped my own approach.”
- Raja Swaminathan, Corporate Vice President of Packaging, AMD

Raja Swaminathan (Ph.D. ‘05) credits his success in semiconductor technology to the problem-solving mindset he developed during his Ph.D. in Materials Science and Engineering at Carnegie Mellon University. Now Corporate Vice President of Packaging at AMD, his career has included influential roles at Intel and Apple, where he helped drive groundbreaking advancements.
His path to CMU began with a bachelor’s degree in metallurgy at IIT Madras, India and a curiosity about the relationship between material structure and properties. Though his first role at Intel wasn’t directly related to his doctoral research, the critical thinking, resilience, and adaptability he gained at CMU proved invaluable in navigating the complexities of the semiconductor industry.
“Earning a Ph.D. forces you to carve your own path- driving new physics and technologies,” he said, reflecting on his experience at CMU. “It teaches you resilience, perseverance and how to solve problems without a playbook.”
At Intel, Swaminathan maintained ties with CMU, collaborating with Professor Michael McHenry on an SRC-funded project that led to the development of solder magnetic nanocompositesmaterials capable of reflow without traditional ovens.
Today at AMD, he oversees the end-to-end development of advanced semiconductor packaging, from early-stage research to high-volume manufacturing. His work enhances silicon performance and enables Moore’s law scaling and accelerating AI capabilities. He also contributes to U.S. Government’s CHIPS Act initiatives, advancing supply chain resilience and workforce development.
Despite his leadership role, Swaminathan remains rooted in fundamental science and engineering principles. “At heart, I’m still a materials scientist. I coach my team to solve problems with the same curiosity and discipline that shaped my own approach.”
In 2024, he was named an IEEE Fellow for his pioneering work on chiplet architectures that have redefined highperformance computing. “Advanced packaging is essential to scaling AI. The IEEE recognition reflects the AMD team’s dedication to pushing boundaries. It wasn’t easy, but the grit I developed at CMU made all the difference.”
Looking ahead, Swaminathan is committed to closing the gap between academic training and industry needs.
“There’s often a disconnect between what students learn and what the industry requires. Bridging that gap is essential to preparing the next generation of engineers for meaningful impact.”
Beyond the lab and executive boardroom, Swaminathan shares insights from his career in semiconductors and the life lessons he’s learned along the way through LinkedIn—inspiring professionals and students alike to think boldly and solve fearlessly.
He continues to engage with CMU’s MSE community to help make that vision a reality.

Embracing fundamentals for future success
Barry Johnson (BS ‘73, Ph.D. ‘83) was honored by the College of Engineering with the Alumni Outstanding Achievement Award this year for his significant leadership in engineering, and in recognition of his significant career accolades including induction into the National Academy of Engineers, being named National Black Engineer of the Year, and being the first U.S. citizen elected to the prestigious Fraunhofer Society.
This award is a prestigious recognition bestowed upon College of Engineering alumni who have demonstrated exceptional accomplishments in their respective professional fields, whether through groundbreaking innovations, influential leadership, or notable advancements that have positively impacted society.
Johnson has made significant contributions as an engineering leader in both industry and academia. In industry, he has held such executive positions as senior vice president and chief technology officer of Honeywell International, Inc. and corporate vice president and chief technology officer of the Semiconductor Products Sector, Motorola, Inc. In particular, he led the team of Motorola engineers and scientists that pioneered the international semiconductor industry’s transition to 300mm silicon wafers for advanced integrated circuit chip fabrication.
Earlier in his career, Barry was a professor of electrical and computer engineering at the University of Arizona. In addition to his innovative research in microelectronic system level integration, he was instrumental in developing the university’s unique educational program in electronic packaging engineering. Following retirement from industry, he returned to his undergraduate alma mater as dean of the College of Engineering at Villanova University.
Alumni Accomplishments
Kenneth Vecchio (BS ‘83) was recognized as a TMS Fellow for outstanding contributions to the practice of metallurgy, materials science, and technology.

Tadashi Furuhara (Ph.D. ‘89) received the AIST Howe Memorial Lectureship award and was recognized as a TMS Fellow for outstanding contributions to the practice of metallurgy, materials science, and technology.
Steven Spurgeon (B.S. ‘09) received the Burton Medal From Microscopy Society of America. The award, which is given annually to a single physical sciences researcher under the age of 40, is the highest honor the MSA bestows upon early-career scientists in the field of microscopy and microanalysis.
Sean Donegan (B.S. ‘10, M.S. ‘11, Ph.D. ‘13) was selected as the Senior Scientist (ST) for Digital Advanced Materials in the Air Force. In this role, he will lead the Air Force’s strategy for digital and computational methods for materials research and development.
Brian Lin (M.S. ‘13, Ph.D. ‘15) was part of a team from ArcelorMittal Global R&D Laboratories that received a Finalist Medal from the American Iron and Steel Institute (AISI) for their collaborative paper titled “A Mesoscale Crystal Plasticity Model to Predict Room-Temperature Deformation and Martensitic Transformation of High Strength Quenching and Partitioning (Q&P) Steels and Validation with Synchrotron X-Ray Diffraction.”

Dylan Lew (B.S. ‘21) was included on this year’s Forbes 30 Under 30 for Energy and Green Tech alongside fellow co-founders of Ecotone Renewables.
Spencer Matonis (Ph.D. ‘24) received funding from the CMU VentureBridge program for his medical startup, Edulis Therapeutics, which seeks to reinvent how patients with chronic GI diseases are treated. Edulis is currently raising seed capital to fund pre-clinical testing of its lead asset, an antiinflammatory implant for Crohn’s disease.
Siya Scindia (B.S. ‘24) and Katherine Wu (B.S. ‘25) received the Outstanding Collegiate Member Award from the Society of Women Engineers (SWE) in 2024 and 2025, respectively. Each year SWE recognizes no more than 20 undergraduates from among their 19,000 student members.
Sirisha Kuchimanchi (M.S. ‘99, Ph’D. ’07) has been awarded an Eisenhower Fellowship, a prestigious program that brings together global leaders to create real-world impact. She will be working on a initiative focused on STEM outreach and workforce development, exploring how digital innovation and handson education can inspire underrepresented communities in fields like semiconductors and advanced manufacturing.


We enjoyed reconnecting with alumni at our annual MSE Deck Party during Carnival Weekend!
Mark your calendars for the next year and join us on Friday, April 9.

Alumni Advisory Council
Members of the MSE Alumni Advisory Council visited campus in the days leading up to Carnival Weekend. They met with students, faculty, and staff, sat in on classes, and provided their expertise on how our department can best serve its students and alumni. We are grateful for their time and feedback!

2025 council members include: (LR) Matthew Walker (M.S. ‘07, Ph.D. ‘10), Bill Slye (B.S. ‘92, M.S. ‘95, Ph.D. ‘00), Jason Harman (B.S. ‘95, M.S. ‘96), Rachel (Ferebee) Maher (M.S. ‘12, Ph.D., 2016), Binky (Patts) Sargent (B.S. ‘90), Stephanie Bojarski (M.S. ‘11, Ph.D. ‘14), Dylan Lew (B.S. ‘21; M.S. ‘21), and James Rogers (BS ‘07)
Not pictured: Michelle Wolf (B.S. ‘14)


MSE entrepreneurs return to inspire students
Each year, the Scott Institute for Energy Innovation invites alumni speakers to share their experiences at its Entrepreneurial Student Lunch Seminars. Last year’s seminars featured two graduates of the materials science and engineering program who are working in startups focused on innovative technologies.
In October, Sam Kernion (M.S. ‘10, Ph.D. ‘12) spoke to students about his role as CEO at CorePower Magnetics, a startup is driving the development of next-gen magnetic components and electric motor technologies that can help EVs go farther, charge faster, and reduce energy needs for growing sectors like data centers. The technology for the company was created at Carnegie Mellon and the National Energy Technology Laboratory (NETL), with Kernion as one of the creators.
Though Kernion worked in industry for several years immediately following graduate school, his entrepreneurial roots began in Mike McHenry’s nanocrystalline alloys research group. Through this group, he met Paul Ohodnicki (M.S. ‘06, Ph.D. ‘08), a CMU graduate from McHenry’s group who was working at NETL at the time while collaborating with CMU on the development of the strain annealing technology behind CorePower. Along with Ohodnicki, who is now CorePower’s chief technology officer, McHenry, Leah Ohodnicki and Kevin Byerly were all cofounders of the company.
“Working at a startup is a very refreshing process — you’re surrounded by people who are at the company because they feel passionate about its
mission, and they’re excited about what it can mean for the region,” said Kernion.
During his visit with CMU’s Scott Institute for Energy Innovation, a guiding question that Kernion presented to a group of entrepreneurial-minded students was: “What problem are you solving?” While the answer wasn’t immediately clear when Kernion completed graduate school in 2012, by the time the technology was patented in 2019, EVs and their charging needs formed a bigger part of the decarbonization conversation. The timing was right for CorePower to officially launch the following year.
Since then, CorePower has received considerable support from the Department of Energy (DOE), including $20 million to develop a manufacturing facility in Pittsburgh for magnetic components and advanced metals that are currently produced by foreign supply chains. Another $1 million from the DOE is earmarked for rare earth-free electric motor development. Both DOE projects serve the goal of increasing domestic manufacturing of transformers, inductors, and electric motors, as rare earth elements are mostly sourced from China.
Kernion noted that spinning a startup out of an academic setting has been a difference maker in how the company has expanded its network.

Sam Kernion

“I think a unique aspect about startups in general is that you think you’re going to be isolated, but there’s a tremendous network — and CMU has been a tremendous partner for us,” he said.
In November, Dylan Lew (B.S./M.S. ’21) was the keynote speaker at the lunch series, sharing his path to entrepreneurship that also started during his time as a CMU student. Lew met a group of like-minded students from the University of Pittsburgh and the University of Michigan who had built the first-ever Portable Farm Aquaponics System in the area.
His first job on that team was to clean the fish tank that supported the aquaponics system and figure out what to do with the biogas produced from the initial design of a biodigester. Today Lew is the CEO and co-founder of Ecotone Renewables, a food waste startup that was born out of the student braintrust that he joined in his first year of college.
“It’s been very busy the past few years,” said Lew, who brought Ecotone Renewables to closer fruition while completing the College of Engineering’s integrated bachelor’smaster’s (IBM) program. “We’ve brought on new investors, and now we’re in the commercialization phase. We’ve deployed and operated eight biodigesters across the Northeast region.”
Food that gets thrown away is responsible for about 8 percent of global greenhouse gas emissions — roughly twice the level of emissions produced by aviation. To combat this common yet inconspicuous environmental hazard, Ecotone Renewables developed the Zero
Emissions Upcycling System (ZEUS) to provide on-site food waste management to a growing number of clients around the northeastern United States. ZEUS works exactly like the stomach, first by grinding up food waste and mixing it with rain water, then transferring the smoothie-like substance from a dosing tank to a stomach tank, where food waste biodegradation happens. This creates two byproducts: a biogas and a liquid fertilizer, known as Soil Sauce, which is available commercially in at least 50 retailers. Local end users include the City of Pittsburgh and Allegheny Health Network, though ZEUS’ reach is growing. Ecotone Renewables recently signed its first international client, Compass Group Canada, a foodservice and hospitality company. Making strides in sustainability can feel hampered by technical breakthroughs that haven’t materialized yet, but Ecotone Renewables is helping clients reduce their food waste in the here and now.
“What’s interesting is that a lot of companies have waste reduction goals but they’re struggling to meet them,” said Lew. “Having a quickto-implement solution, like ZEUS, can give clients a pretty big jump on meeting those goals.”

Share your news for the next MSE magazine!
Dylan Lew
Carnegie
Materials Science & Engineering Department
Carnegie
mse.engineering.cmu.edu

Support our students
Over the past year, support for the MSE Student Impact Fund has helped our students ignite their passion for discovery. Students have used these funds to travel to exciting conferences and networking events where they are able to share their research, participate in activities such as a newly formed Forging Club, and work on their projects using state-of theart lab equipment and computational tools.
We appreciate the ongoing generosity of our students from our alumni and friends.
